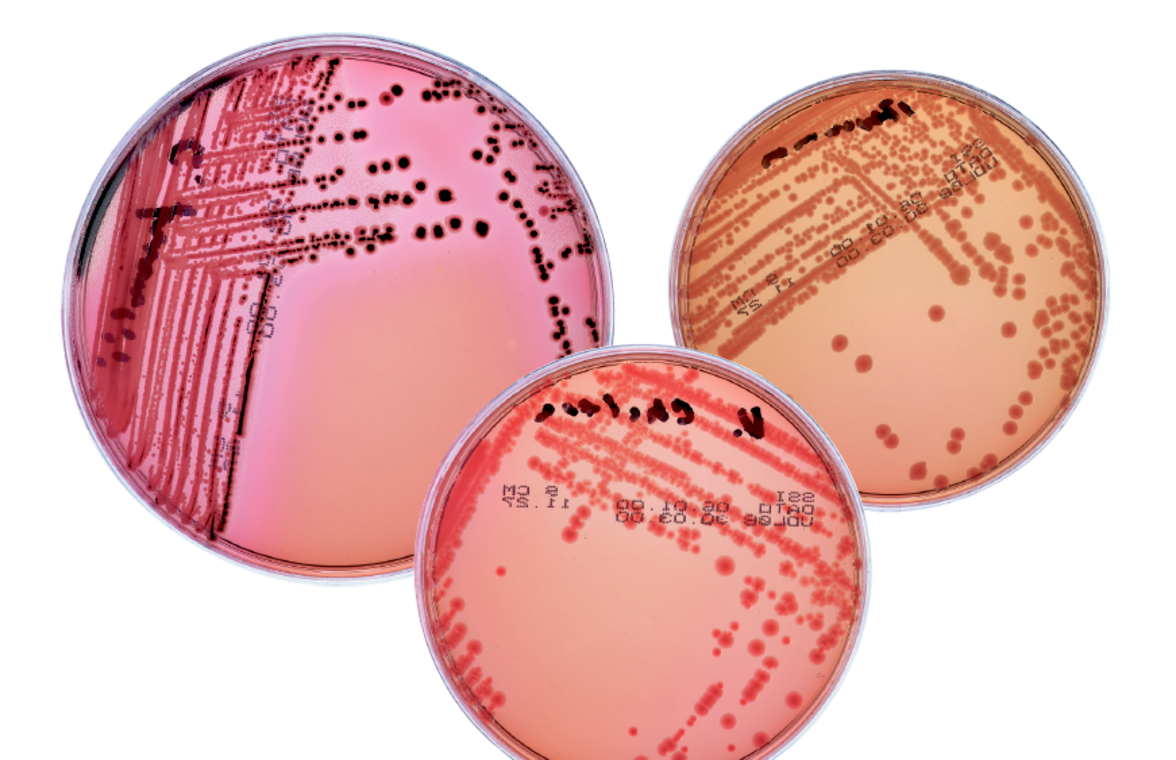
Готовые питательные среды Российского производства для санитарной и промышленной микробиологии
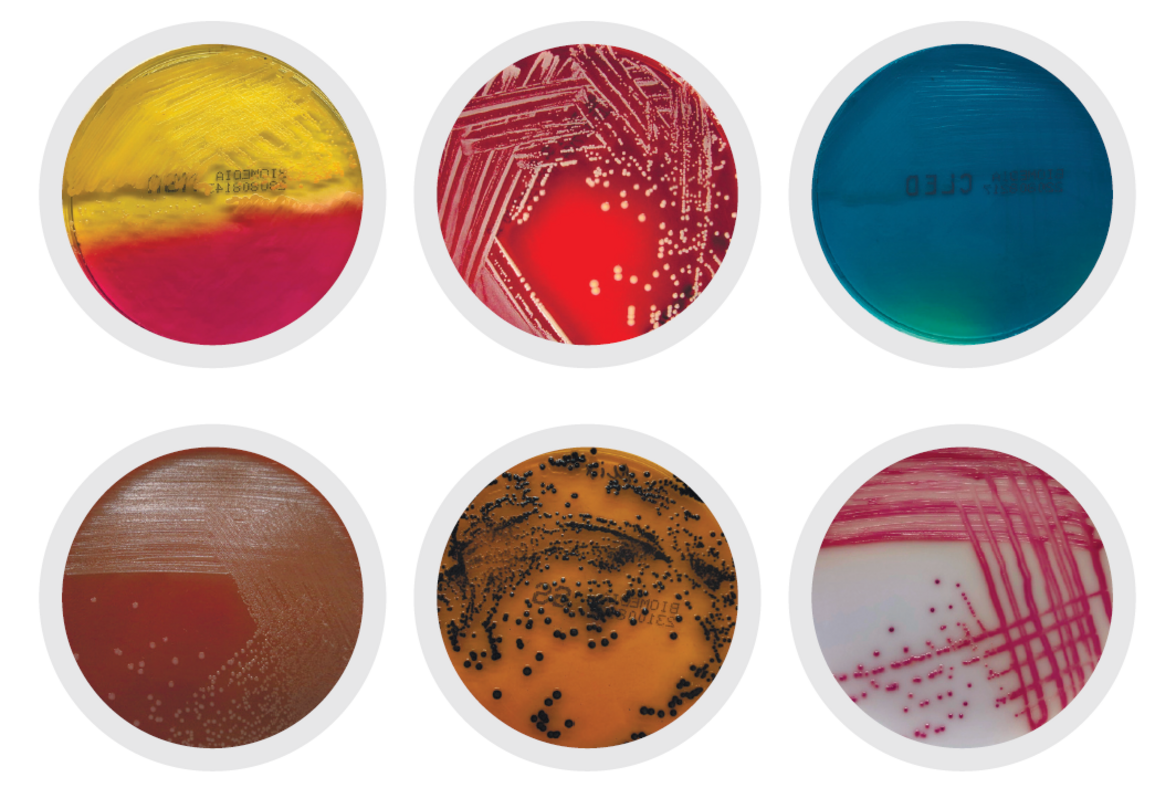

Рады сообщить, что в нашем Каталоге появились готовые питательные среды Российского производства для санитарной и промышленной микробиологии:

Оперативные поставки и отличные сроки годности.
Присылайте ваши заявки на info@microbius.ru

Оперативные поставки и отличные сроки годности.
Присылайте ваши заявки на info@microbius.ru
Первыми получайте новости и информацию о событиях